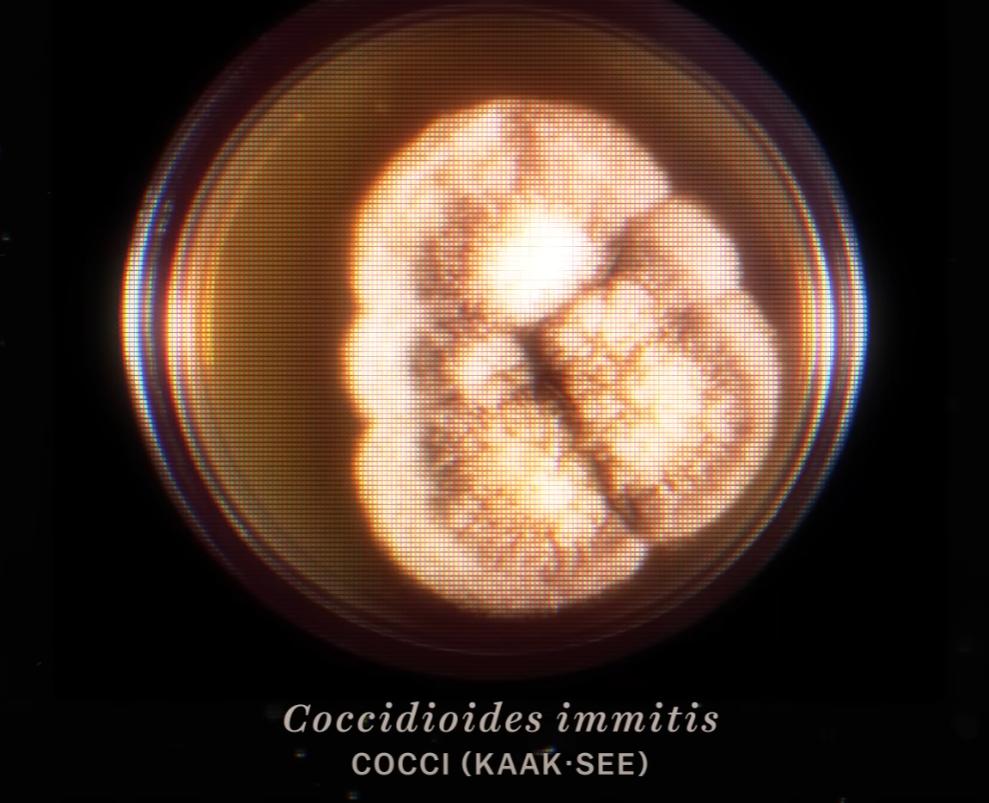
可感染人类的沙漠真菌是如何传播的？

#头条创作挑战赛#
在全世界数以百万计的真菌物种中,只有几百个物种会致使人类生病,而球孢子菌就是其中之一。
球孢子菌的孢子会导致人类感染重大疾病,但这种致命的威胁却不是这种真菌最神奇的地方,它们诡异的传播形式才是让科学家摸不着头脑的地方。
众所周知,大多数真菌喜欢待在黑暗、潮湿以及通风良好的环境中,但球孢子菌生活的地方却是在炎热的沙漠地区。
此外,与其他真菌以死去的腐质生物为食不同,球孢子菌不会等待动物死亡之后再开始享受美食,而是在它们还活着的时候,就从内到外开始进行消化。这种进食方式已经持续了数千年。

尽管如此,我们对这种真菌依然知之甚少,例如它到底是怎么传播的?
首先球孢子菌主要分布在北美洲和南美洲的沙漠或荒漠地区,由它所引起的疾病有许多名称,例如球孢子菌病、沙漠风湿病、河谷热或溪谷热。
其症状与普通的流感比较相似,例如发烧、身体酸痛、疲惫等,通常会持续一个多月,但有些人的情况更严重,会出现慢性肺部疾病、皮肤脓肿或脑膜炎,这将是致命的。
幸运的是,这种病例爆发非常罕见,几乎97%都发生在美国的亚利桑那州和加利福尼亚州,但在2014年,在华盛顿也出现了球孢子菌病,这意味着它们从沙漠“走”出来了,但对于它们是如何移动的以及究竟会去往何处,我们还不得而知。
基于现有的研究,科学家认为可能有三种不同的方式在驱动这种真菌的传播,首先要从它们的居住环境说起。
球孢子菌本身很奇怪,它们可以直接在沙漠中生长,就像其他真菌可以在一块面包上扩张自己的领土,球孢子菌会将大片沙漠变成它的领地,但在其他动物看来,这片沙漠并无两样。

因此在这种情况下, 想要追踪它们的痕迹就变得非常困难 ,除非沙漠地面受到干扰。此时球孢子菌会将孢子释放到空气中,然后被毫无戒心的哺乳动物捕获。
一旦被吸入进身体,它们会盘踞在肺部,并转换成新的形态,成为在动物体内繁殖的寄生虫,并且可以长到肉眼可见的大,约为0.1厘米,然后就可以观察到肺部组织病变。
当然,它们也不是那么急着要开始“吃”,实际上,它们可以潜伏在肺部相当长的时间,毕竟不活跃是一个很好的策略,这样被寄生的动物也无法察觉到它的存在,然后只需要耐心等待时机即可。
并且,它们对定居的肺部来源完全不挑剔,在已发现的感染病例中,从人类到狗甚至是海豚,几乎任何类型的哺乳动物都都是它的目标,由此也可以推测出球孢子菌的第二种传播方式: 潜伏在活着的沙漠啮齿动物中。
当生活在沙漠中的某只更格卢鼠想找个地方休息时,它们会使用传统技能:打洞。此时,它们的前爪上下翻飞,沙子被刨得老高,少数散落在老鼠身上,这时候,球孢子菌表示: 我已着陆,感觉良好。

接下来,这种跳鼠体内将携带球孢子菌四处活动,直到体内的寄生虫逐渐蚕食老鼠的脊柱,这便是球菌的另一种策略。
当老鼠死后,球孢子菌又重回地面继续隐匿,直到被另一种生物再次吸入。
就这样,随着沙漠中的啮齿动物被寄生的越来越多,球孢子菌可以“走”到更远的地方。
既然球孢子菌可以勾搭上沙漠中的啮齿动物外,那么自然也可以坐上“顺风车”,这就引出它们的第三种传播方式: 依靠自然天气传播。
我们都知道在沙漠中,大风甚至沙尘暴都并不罕见,狂风卷起的泥沙可以让球孢子菌瞬间移动到千里之外。

另一方面,如果沙漠中降雨量增多,必然会带来更多地生机,从而涌现更多的“传播使者”。
总之,球孢子菌的传播可能是由于以上这些因素,但仍然有许多未解决的问题。
不过可以确定的是,科学家正尝试在沙漠中安装*踪器追**试图寻找球孢子菌的痕迹,如果可以知道它们的传播路径,或许就能提前进行预防。
同时,研究人员也正在开发可以预防的疫苗,目前已经在老鼠和狗的身上得到了验证,不过还是建议大家不要参与环境中有很多粉尘的活动,而且戴口罩依然是有用的。